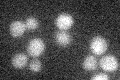
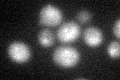

View description
Subunit 8 of ubiquinol cytochrome-c reductase complex, which is a component of the mitochondrial inner membrane electron transport chain; oriented facing the intermembrane space; expression is regulated by Abf1p and Cpf1p
Localization:
Intensity:
Fold change:
Significance:
-
C’ GFP library in SD
below threshold14.53 -
N' NOP1pr-GFP in SD

nucleusN/A -
N' TEF2pr-mCherry in SD

cell periphery,vacuoleN/A -
N' NATIVEpr-GFP in SD

missing0 -
N' TEF2pr-VC and Cyto-VN in SD

#N/A0 -
C’ GFP library in SD+DTT
cytosol17.641.21No -
C’ GFP library in SD+H2O2

cytosol15.291.05No -
C’ GFP library in Starvation Media

cytosol13.490.92No -
C’ GFP library on the background of Pup2-DaMP

below threshold -
C’ GFP library on the background of CCT mutant

below threshold13.45590.925699No
